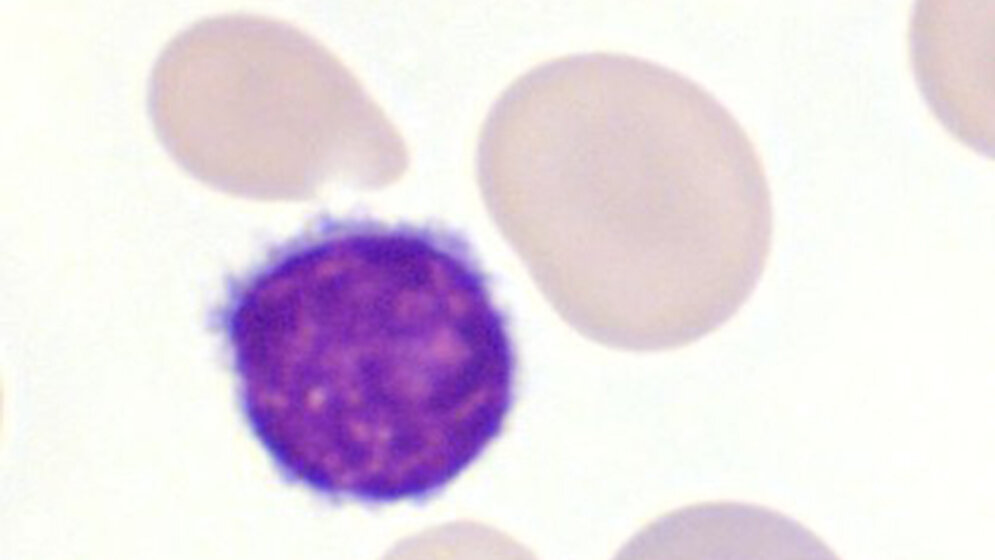
Klinische Bedeutung (Teil 2)

Die Retikulozyten(RE)-Bestimmung ist elementarer Bestandteil jeder Anämiediagnostik. Diskrepant zur Bedeutung für die Klassifikation einer Anämie werden die RE häufig nicht entsprechend verwendet.
Entnommen aus MTA Dialog 08/2014
Sie möchten die Zeitschrift abonnieren und auf alle Inhalte zugreifen?
Dann nutzen Sie jetzt unser Probe-Abonnement mit 3 Ausgaben zum Kennenlernpreis von € 19,90.
Jetzt Abonnent werden